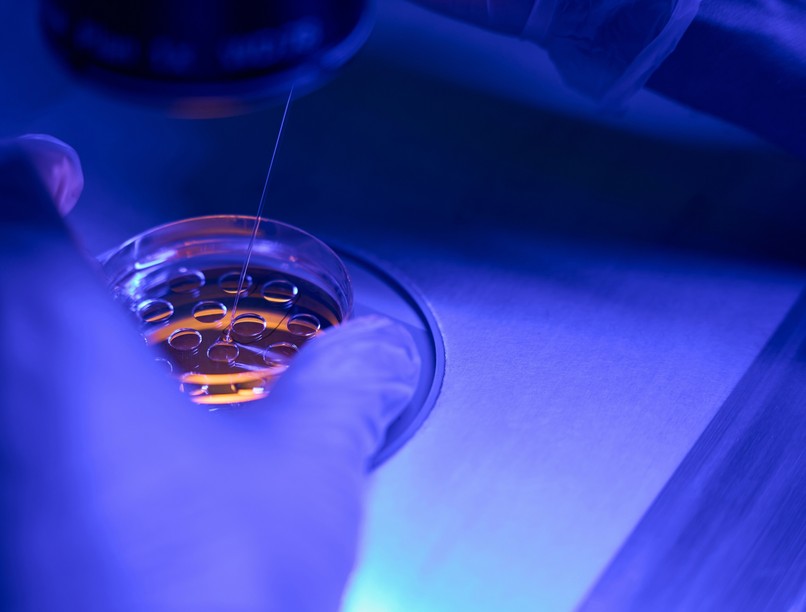
mire jó biopszia menete rák elváltozás tumor jele

Mikor van szükség biopsziára? Hogyan végzik? Mikor és melyik típus indokolt?
A biopszia legismertebb alkalmazási területe az onkológia. A minták alapján meghatározható, hogy egy-egy gyanús sejtburjánzás daganatos-e vagy sem. A szövetmintát ellenőrzik és elemzik, így a szakemberek meghatározhatják, hogy milyen további lépésekre van szükség.
Mi a biopszia?
A biopszia diagnosztikai eljárás, melynek során apró szövetmintát vételeznek a test meghatározott részéről, és azt megfelelő előkészítés után mikroszkóp alatt megvizsgálják. A szövetmintán további vizsgálatokat is elvégezhetnek, mint például az esetleges kórokozók kitenyésztését. Elsősorban a rákdiagnosztikában alkalmazzák. Újonnan felfedezett csomó, vagy daganat esetében nagy bizonyossággal kimutatható, hogy az elváltozás jó- vagy rosszindulatú (benignus, vagy malignus). Máj- és vese-biopsziát olyan betegségek esetén is végezhetnek, amikor a megfelelő kezelés kiválasztásához részletes diagnózis szükséges.
Hogyan végezhetik a biopsziát?
A biopszia egy meglehetősen elterjedt diagnosztikai eljárás, melynek lényege, hogy a testből eltávolított szövetet vagy sejthalmazt megvizsgálnak, elemeznek, és ennek alapján nemcsak azt állapíthatják meg, hogy jelen van-e a szervezetben valamilyen betegség, hanem az információk segítségével az esetleges későbbi terápiát is hatékonyabban tervezhetik meg. A biopszia természetesen legismertebb, legelterjedtebb alkalmazási területe az onkológia: a szakorvosok a minták alapján határozhatják meg, hogy egy-egy sejtburjánzás vagy gyanús szövetdarab daganatnak (esetleg jó- vagy rosszindulatúnak) számít-e.
A mintavétel több módon is történhet, attól függően, hogy mely területről, milyen szövetekből és milyen betegség gyanúja esetén kívánnak több információt szerezni. A leggyakrabban endoszkóppal, tűvel vagy szikével, vagyis kimetszéssel végzik a biopsziát. Az endoszkópos mintavétel esetén egy rugalmas, hajlékony, vékony csövet vezetnek be a szervezetbe. Az endoszkóp végén egy apró kamera és lámpa, illetve egy mintavételi eszköz található. A szakorvos "kívülről" irányíthatja az eszközt, és egy képernyőn követheti az endoszkóp útját. Amikor a megfelelő helyre érkezik az endoszkóp, mintát vesz a kérdéses szövetből, majd ezt "visszahozza" a külvilágra. Endoszkópos módszerrel vehetnek szövetmintát a tüdőből vagy a belekből.
Tű segítségével is mintát vehetnek, elsősorban azokból a szövetekből, melyek a bőr felszínéhez közel helyezkednek el, vagy amelyek helye kívülről is pontosan megállapítható. Szintén tűvel vehetnek csontvelő-mintát a nagyobb csontokból (általában a csípőcsontból); ez olyan betegségek gyanújánál lehet szükséges, amikor a vérrel, esetleg az immunrendszerrel van valamilyen probléma, vagy lehetségesnek tartják, hogy a rákos megbetegedés a csontokat is megtámadta.
Kimetszéssel például nagyobb bőrfelületről távolíthatnak el mintát. A "nagyobb" természetesen relatív, hiszen általában egy centiméternél is kisebb az a szövetdarab, amit később megvizsgálnak. A kimetszés történhet szike vagy egy speciális, kerek vágóeszköz segítségével, de az is előfordulhat, hogy penge segítségével csak "lekaparják" a bőrfelületet.
A kapott és előkészített (pl. megfestett) mintát aztán mikroszkóp alatt vizsgálja meg egy patológus szakorvos, aki képes felismerni és azonosítani a kóros, a normálistól eltérő sejteket; bizonyos esetekben a szövetminták kémiai elemzésére is sor kerülhet.
A mintavétel kétféle módon, vékony vagy vastagabb tűvel történhet
Magyarországon leggyakrabban a vékony tűvel végzik, ami pici kellemetlenséggel járhat, de érzéstelenítéssel még ezen is igyekszenek enyhíteni. A vizsgálat során egy vékony tű segítségével kis szúrást ejtenek, így lehetővé válik, hogy a kérdéses területről sejtmintát vegyenek, amit további vizsgálatra küldenek. A sejtmintából megállapítható az, hogy jó- vagy rosszindulatú elváltozásról van szó.
Mindenesetre szörnyű nagy fájdalmaktól, hatalmas tortúrától egyáltalán nem kell tartanunk, és a tűszúrásnak hála hamar megbizonyosodhatunk felőle, hogy mi a baj.
Nem csak daganatos betegségek esetén végzik
Bár a leggyakrabban daganatos betegeknél, vagy daganatos betegségek gyanújánál végeznek biopsziát, számtalan más esetben is szükség lehet a mintavételre. Például gyulladásos bélbetegségeknél, veseproblémáknál, májbetegségeknél, fertőzéseknél (ilyenkor a megnagyobbodott nyirokcsomókból vehetnek mintát), vagy gyulladásos érbetegségek esetén.
A betegség meghatározása mellett a biopszia segítségével követhetik például a beteg állapotának romlását vagy javulását, a terápia hatékonyságát, de transzplantáltak esetén azt is, hogy a szervezet képes volt-e befogadni a beültetett szervet.
A visszahívás és a biopszia még nem jelent rákot!
A mammográfiás szűrésen részt vevő hölgyek 3-5 százalékát hívják vissza, mert olyan elváltozást látnak a felvételen, amelyet szükséges tovább vizsgálni újabb, ezúttal részletesebb mammográfiával vagy ultrahanggal. Esetenként tűbiopsziás mintavételre is szükség lehet, ám a tisztázó vizsgálatok után a betegeknek csak 0,5-1 százalékánál van szükség műtéti beavatkozásra.
Olvasta már?
- Nyirokrák: ezekkel a szokatlan tünetekkel jelezhet a tumor
- Csomó a bőr alatt: így ismerheti fel a limfóma tüneteit
- Mi a teendő, ha göbös a pajzsmirigy?
Rossz szokások, amelyek növelhetik a szívritmuszavar esélyét
Kövesse az Egészségkalauz cikkeit a Google Hírek-ben, a Facebook-on, az Instagramon vagy a X-en,Tiktok-on is!